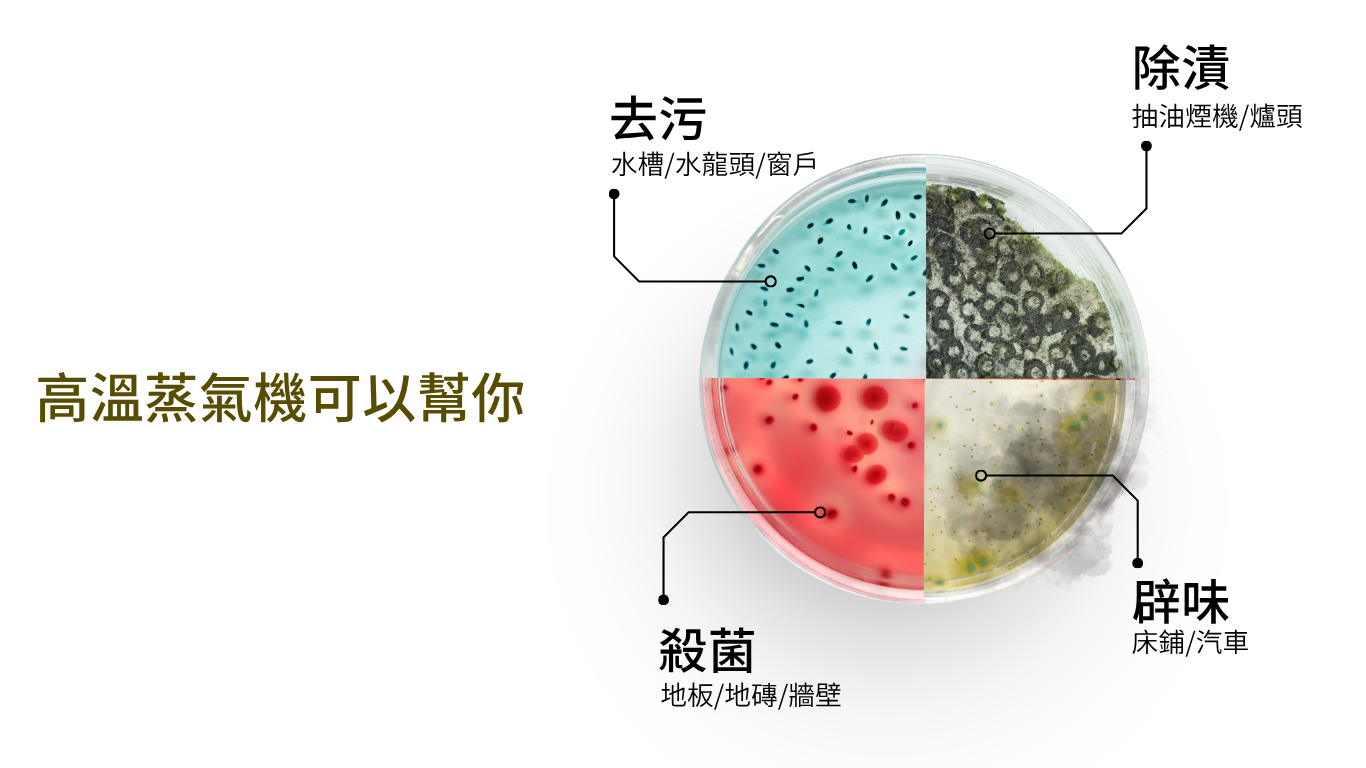

過敏人士
已經奮力打掃,為何過敏仍不見好轉?光靠抹布與清潔劑根本無能為力

長者及兒童家庭
化學清潔劑刺激皮膚與呼吸道,對免疫力弱者有風險:溼滑地面更增加長者跌倒機會

傭人家庭
繁瑣清潔佔用時間,影響照顧家人:多種清潔劑易致手部過敏,殘留更可能污染食物與兒童用品

寵物家庭
已經奮力打掃,為何過敏仍不見好轉?光靠抹布與清潔劑根本無能為力
高溫蒸氣可殺滅哪些細菌病毒?
高温蒸氣(攝氏140-180*C)經實驗驗證實可殺減99.9% 常見家居病菌,包括:
・大腸桿菌:常見於廚房、水槽、寵物排泄處
・金黃色葡萄球菌:可引發皮膚感染,常藏於床舗與抹布
・沙門氏菌:與食物中毒有關
・白色念珠菌:易在潮濕環境滋生,如浴室與洗衣機內壁
・塵蟎與其排泄物蛋白:是哮喘與鼻敏感元兇
・流威病毒、冠狀病毒 (如 HINI、SARS-COV-2 類型):實驗條件下可有效坡壊病毒結構

應 用 範 圍

廚房
不鏽鋼水槽
牆壁
抽油煙機
雪櫃

客廳
地板/地磚
牆壁
沙發

廁所
水龍頭
牆壁
玻璃
洗衣機

睡房
衣服熨燙
床鋪
窗簾
冷氣機









